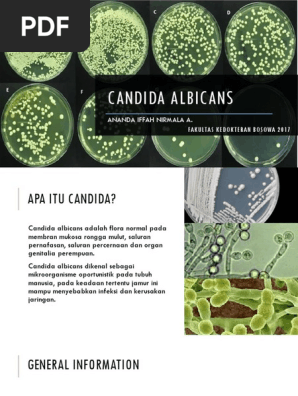

Product id: Candida on sale albicans adalah
Candida albicans Wikipedia on sale, Candidiasis Gejala penyebab dan mengobati Alodokter on sale, Role of Candida albicans in Oral Carcinogenesis Universitas on sale, Candidiasis Gejala Penyebab dan Pengobatan Halodoc on sale, Candida albicans Wikipedia bahasa Indonesia ensiklopedia bebas on sale, Candida Albicans Jamur Infeksi pada Tubuh Hello Sehat on sale, 3 Jenis Infeksi Candida Albicans yang Paling Umum on sale, Candida albicans Doctor Fungus on sale, Everything You Need to Know About Candida Albicans on sale, Kandidiasis Penyebab Gejala dan Cara Mengobatinya on sale, Infeksi Jamur Candida albicans Diabetes Mellitus dan Nilai A1c on sale, R.ANGGREK KLINIK VCT KEDIRI Candidiasis atau kandidiasis on sale, Jangan Disepelekan Inilah Cara Ampuh Mengobati Candidiasis on sale, 3 Jenis Infeksi Candida Albicans yang Paling Umum on sale, 6 Penyakit yang Dapat Terjadi Akibat Jamur Candida Albicans on sale, Kandidiasis Oral patofisiologi diagnosis penatalaksanaan on sale, Blastospora a and Pseudohypa b Candida albicans on several on sale, Candida Albicans Jamur Infeksi pada Tubuh Hello Sehat on sale, Candida Albicans Mikrobiologi PDF on sale, Candida Lebih dari 1.917 Gambar Ilustrasi Stok yang Dapat on sale, Pengaruh Lingkungan Terhadap Pembentukan Biofilm Candida albicans on sale, Generasi Biologi Candida albicans adalah spesies patogen dari on sale, The growth colony of Candida albicans on several alternative media on sale, Recurrence Vaginal Candidiasis DTAP Clinic on sale, Bakteri candida albicans Stok Foto Bakteri candida albicans on sale, China OEM Manufacturer Candida Albicans Adalah Neisseria on sale, Buku Paket Kelas 9 IPA Semester 1 on sale, Infeksi Jamur Candidiasis Bisa Sebabkan Kematian Benarkah on sale, Jangkitan Candida Albicans on sale, Direktorat Jenderal Pelayanan Kesehatan on sale, Candida Albicans Perangaimu Tak Secantik Namamu Kompasiana on sale, Foto Sains Bakteri Candida Albicans Adalah Ragi Patogen on sale, Perhatikan gambar penyakit pada system reproduksi on sale, Candida Lebih dari 1.917 Gambar Ilustrasi Stok yang Dapat on sale, Kandidiasis Oral pada Bayi Alomedika on sale.
Candida albicans Wikipedia on sale, Candidiasis Gejala penyebab dan mengobati Alodokter on sale, Role of Candida albicans in Oral Carcinogenesis Universitas on sale, Candidiasis Gejala Penyebab dan Pengobatan Halodoc on sale, Candida albicans Wikipedia bahasa Indonesia ensiklopedia bebas on sale, Candida Albicans Jamur Infeksi pada Tubuh Hello Sehat on sale, 3 Jenis Infeksi Candida Albicans yang Paling Umum on sale, Candida albicans Doctor Fungus on sale, Everything You Need to Know About Candida Albicans on sale, Kandidiasis Penyebab Gejala dan Cara Mengobatinya on sale, Infeksi Jamur Candida albicans Diabetes Mellitus dan Nilai A1c on sale, R.ANGGREK KLINIK VCT KEDIRI Candidiasis atau kandidiasis on sale, Jangan Disepelekan Inilah Cara Ampuh Mengobati Candidiasis on sale, 3 Jenis Infeksi Candida Albicans yang Paling Umum on sale, 6 Penyakit yang Dapat Terjadi Akibat Jamur Candida Albicans on sale, Kandidiasis Oral patofisiologi diagnosis penatalaksanaan on sale, Blastospora a and Pseudohypa b Candida albicans on several on sale, Candida Albicans Jamur Infeksi pada Tubuh Hello Sehat on sale, Candida Albicans Mikrobiologi PDF on sale, Candida Lebih dari 1.917 Gambar Ilustrasi Stok yang Dapat on sale, Pengaruh Lingkungan Terhadap Pembentukan Biofilm Candida albicans on sale, Generasi Biologi Candida albicans adalah spesies patogen dari on sale, The growth colony of Candida albicans on several alternative media on sale, Recurrence Vaginal Candidiasis DTAP Clinic on sale, Bakteri candida albicans Stok Foto Bakteri candida albicans on sale, China OEM Manufacturer Candida Albicans Adalah Neisseria on sale, Buku Paket Kelas 9 IPA Semester 1 on sale, Infeksi Jamur Candidiasis Bisa Sebabkan Kematian Benarkah on sale, Jangkitan Candida Albicans on sale, Direktorat Jenderal Pelayanan Kesehatan on sale, Candida Albicans Perangaimu Tak Secantik Namamu Kompasiana on sale, Foto Sains Bakteri Candida Albicans Adalah Ragi Patogen on sale, Perhatikan gambar penyakit pada system reproduksi on sale, Candida Lebih dari 1.917 Gambar Ilustrasi Stok yang Dapat on sale, Kandidiasis Oral pada Bayi Alomedika on sale.